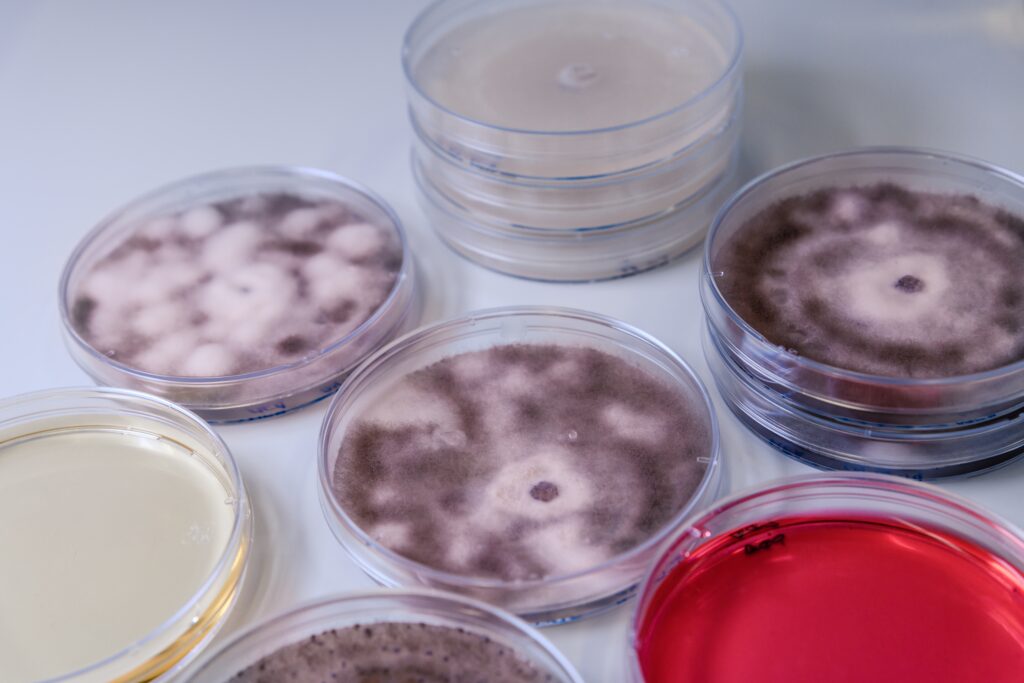
A high angle closeup shot of Petri dishes with different substances

- +27 82 786 4222
- info@drdeevetconsult.com
Dr. Dee’s Veterinary Consultancy is a leading veterinary consultancy firm with a deep understanding of South Africa’s unique agricultural landscape. With over 22 years of experience, Dr. Dee has worked extensively in the Gauteng Provincial Veterinary Services, including five years as the head of provincial veterinary services. During this time, she served as the Provincial Executive Officer for the Meat Safety Act, leading a team of qualified veterinary and para-veterinary professionals, as well as meat inspectors.
Dr. Dee’s leadership was instrumental in managing the control of major animal diseases with significant economic impact, such as Foot-and-Mouth Disease, Highly Pathogenic Avian Influenza, African Swine Fever, and Rabies. She also pioneered the implementation of Primary Animal Health Care services for small-scale farmers and historically disadvantaged communities.
At Dr. Dee’s Veterinary Consultancy, we specialize in providing comprehensive services aimed at improving animal health, ensuring food safety, and supporting farming enterprises. We are committed to addressing the gap between the well-developed commercial farming sector and the underdeveloped small-scale and communal farming sector. Our goal is to create sustainable pathways for small-scale farmers to participate fairly in the formal livestock economy and access opportunities in international trade.
With a team of experienced veterinarians and animal health experts, we offer tailored solutions that foster growth, sustainability, and inclusion for all sectors of the farming community.
Mission Statement
Our mission is to strengthen the livestock economy by providing expert consultancy services that enhance animal health, ensure food safety, and empower farming enterprises to access and thrive in formal markets. Through tailored solutions, we support small-scale and commercial farmers alike, helping them integrate into value chains that promote sustainability, productivity, and market competitiveness. By focusing on disease management, food safety, biosecurity, and regulatory compliance, we play a vital role in facilitating participation in both local and international trade.
Vision Statement
Our vision is to be a driving force in the transformation of the livestock economy, recognized for empowering farmers to participate fully in sustainable value chains and competitive markets. We aim to be the leading veterinary consultancy that fosters inclusive growth, ensuring both small-scale and commercial farmers benefit from innovative, high-quality services that enhance animal health, food safety, and market access, locally and internationally.
Services Offered

Project Management Services for Animal Health Programs & Projects
We provide end-to-end project management services for organizations, including government bodies, universities, and community development initiatives. Our focus spans the livestock, piggery, and poultry farming sectors, particularly for small-scale farmers. Services include:
• Comprehensive management of animal health projects, from initial planning to successful completion
• Stakeholder coordination, working with government agencies, NGOs, private entities, and communities
• Monitoring, evaluation, and reporting to ensure project goals are met on time and within budget
• Specialized services such as pasture revitalization, ensuring sustainable farming practices
We are currently managing a 3-year farmer training program funded by a mining trust, aimed at developing communities around their operations.


Education
& Awareness on
Zoonotic Diseases
Raising awareness and providing education on zoonotic diseases is essential for both farmers and public health. Our services include:
• Development and distribution of educational materials for farmers, health workers, and communities
• Workshops, seminars, and training sessions to spread knowledge on disease prevention and control
• Collaboration with health authorities to enhance awareness and implement prevention strategies

Education & Awareness on Safety of Food of Animal Origin
We ensure that both producers and consumers are well-informed about the safety of animal-derived food products. Our services include:
• Training and resource provision on best practices for maintaining food safety from farm to table
• Public awareness campaigns aimed at educating consumers on food safety standards
• Advisory services for producers to help them comply with national and international food safety regulations





Advisory
Services on
Farm Biosecurity
Protecting farms from infectious diseases is a cornerstone of sustainable agriculture. We offer:
- Evaluation of existing biosecurity measures and tailored recommendations for improvement
- Design and implementation of biosecurity protocols to safeguard livestock health
- Training farm personnel on biosecurity best practices and emergency response planning


Advisory Services
on Controlled Animal Diseases
We provide expert advice to help farmers and organizations manage regulated animal diseases, ensuring compliance with legal requirements. Our services include:
- Guidance on disease identification, prevention, and control measures
- Assistance with disease management plans and adherence to national and international standards
- Liaison with veterinary authorities to ensure compliance with disease control regulations


Advisory Services on Exports of Animals and Food of Animal Origin
Exporting animals and animal-origin products requires careful navigation of regulatory frameworks. We provide:
- Consulting on regulatory requirements for the export of live animals and animal products
- Assistance with documentation and certification, ensuring compliance with import/export regulations
- Advisory services on market access and exploring trade opportunities in different regions


Advisory Services on Design & Development of Business Model Canvas for Farming Enterprises
We provide strategic consulting services to assist farming enterprises in developing business models that are both viable and sustainable, tailored to the specific challenges and opportunities within the agricultural sector. Our services include:
- Custom Business Model Canvas workshops, designed to align farming enterprises’ activities with market demands and industry trends, ensuring long-term success
- Strategic support for revenue optimization, helping farmers identify and diversify revenue streams to enhance financial stability
- Ongoing advisory services to streamline business processes, improve customer relationships, and ensure alignment with both local and global market opportunities
We recognize the diverse needs of both commercial and small-scale farming sectors, and our approach is focused on creating adaptable, resilient business models that foster growth in competitive markets.


Advisory Services on Interpretation and Practical Application of South African Veterinary Legislation
We offer expert guidance on understanding and applying South African veterinary legislation, including the Animal Diseases Act and the Meat Safety Act, to ensure compliance and promote best practices in the agricultural and food industries. Our services are designed for both private clients and government institutions and include:
- Interpretation of key regulations related to animal health, disease control, and food safety, ensuring clients are fully compliant with legal requirements
- Advisory services on practical application of legislation, helping farming enterprises, abattoirs, and related businesses implement strategies that meet regulatory standards
- Support for government entities, offering consultation on policy development, compliance strategies, and public health protection initiatives
Our in-depth knowledge of South African legislation enables us to provide clear, actionable advice that helps safeguard animal health, food safety, and the integrity of agricultural operations.


Abattoir and Value
Chain Facilitation
We provide strategic advisory and operational support in the abattoir space, focusing on enabling small-scale and communal farmers to integrate into value chains. Our services include:
- Facilitating access to abattoir facilities for under-resourced farmers to help them meet market standards
- Advising on compliance with regulatory standards in processing and food safety
- Creating pathways for small-scale farmers to connect with formal markets and explore export opportunities through value chain development

Why Choose Us
Experienced
Expertise in a wide range of veterinary and animal health services
Connected
Strong network with industry stakeholders, including regulatory bodies and international partners

Knowledgeable
Commitment to continuous education and up-to-date knowledge on the latest industry standards
Tailored
Tailored solutions that address specific challenges faced by our clients
Meet The Team
Discover the talented professionals who are the driving force behind Dr Dee’s Veterinary Consultancy. Our team is composed of industry leaders with extensive experience in veterinary science, biosecurity, project management, and business development. Each member plays a crucial role in delivering the expert guidance and personalized solutions that help our clients achieve healthier livestock, safer food products, and successful farming operations.
Client Testimonials
© 2024 Dr Dee’s Veterinary Consultancy • All Rights Reserved


